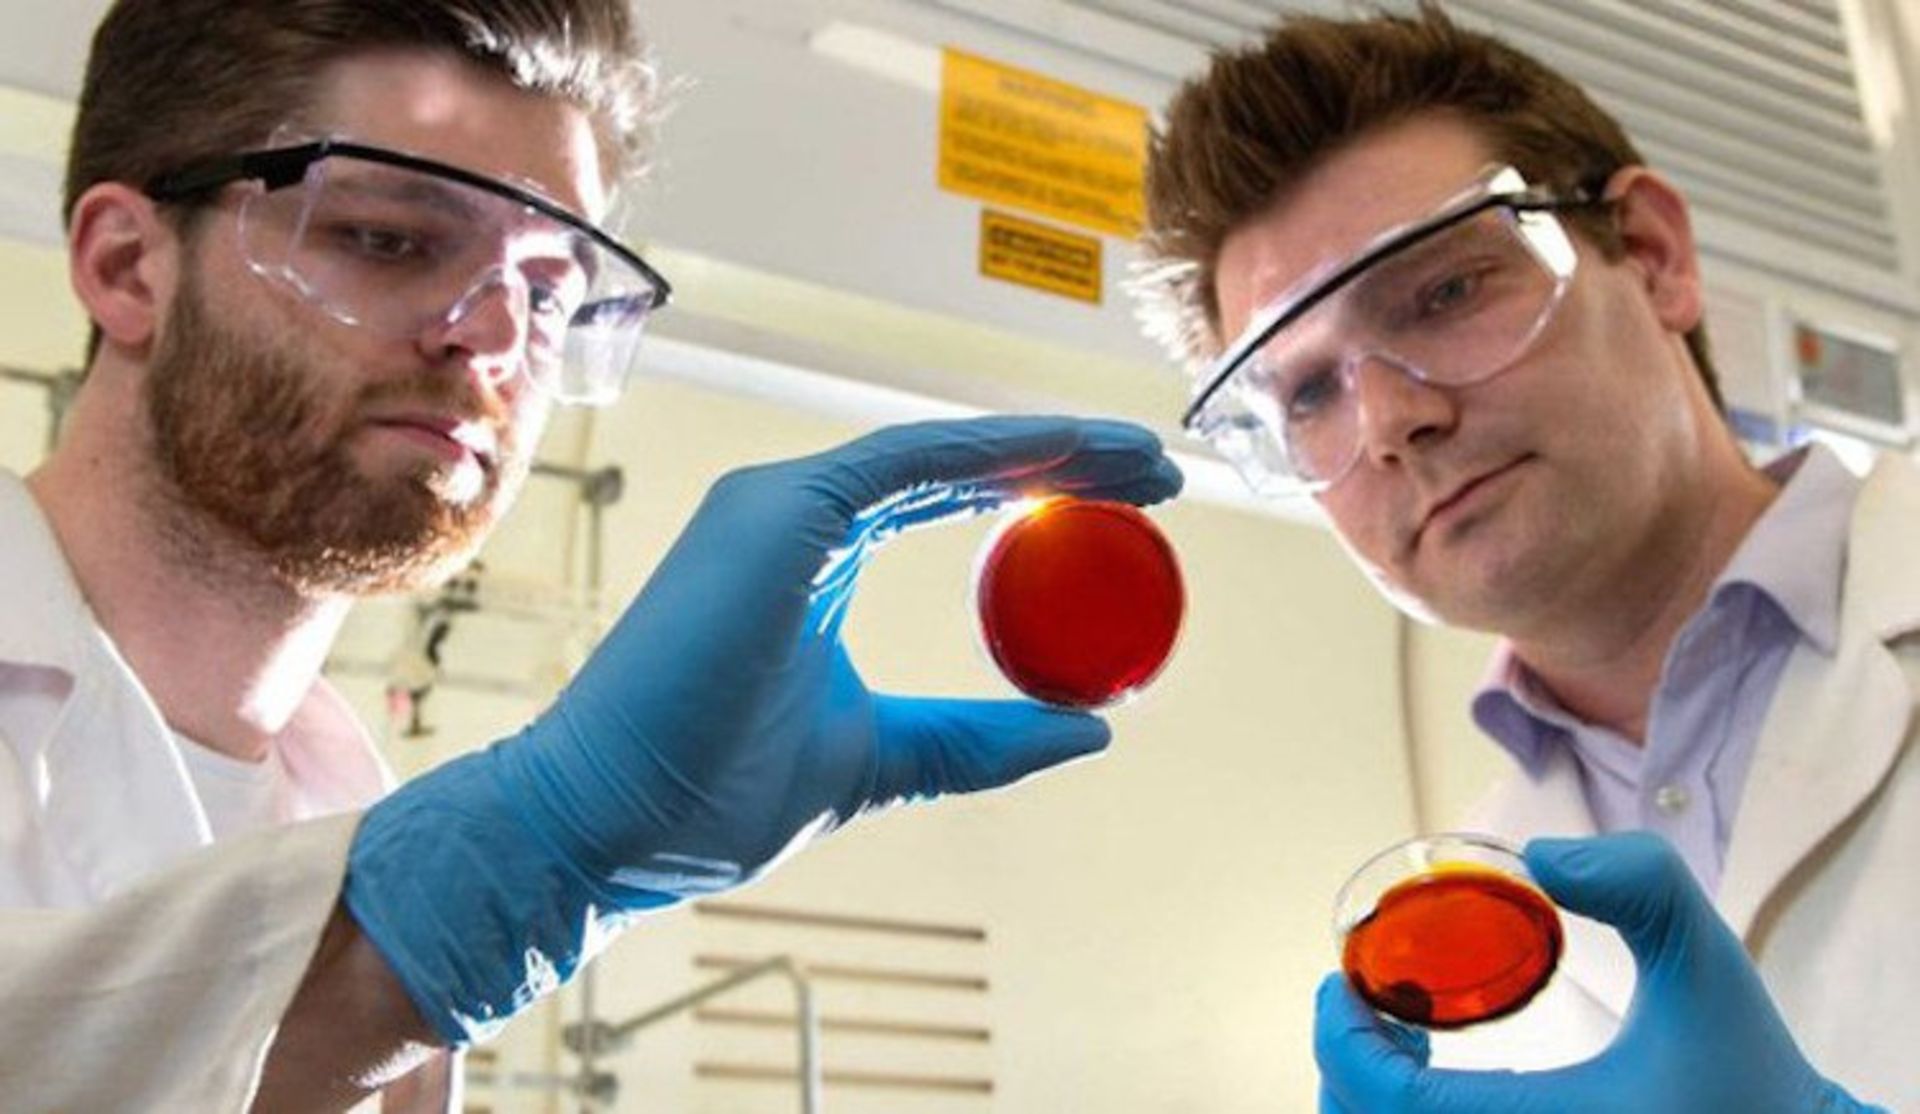

کشف تصادفی روشی برای حذف جیوه از آب، به کمک پوست پرتقال
دکتر چاکر دربارهی این کشف اینگونه گفت:
آلودگی جیوه خیلی از مناطق دنیا را تحت تاثیر قرارداده است. جیوه بر روی غذا و آب تاثیر میگذارد و باید برای حذف آن راههای مفید و به صرفه پیدا کرد.
دکتر ورتینگتون و دکتر چاکر به دنبال ساخت یک نوع پلاستیک پلیمری از مواد در دسترس بودند که بتواند آب را از وجود آلایندگیها پاک کند. این دو آزمایشات خودشان را با سولفور که یک محصول جانبی صنایع نفتی است و همچنین لیمونن که روغن گرفته شده از پوست پرتقال است آغاز کردند. ;دکتر چاکر دربارهی انتخاب مواد گفت:
ما سولوفور را انتخاب کردیم چرا که ۷۰ میلیون تن از این ماده در سال توسط صنایع نفتی تولید میشود و از آنجایی که یک محصول جانبی است، استفادههای فراوانی ندارد. لیمونن نیز در سال ۷۰ هزار تن تولید میشود و همچنین بسیار ارزان است چرا که منبع آن روی درخت رشد میکند.ما سولفور و لیمونن را به عنوان دو مادهی اصلی انتخاب کردیم. ما توانستیم این دو ماده را با یکدیگر ترکیب کنیم و یک پلاستیک قرمز رنگ تولید کردیم. این ماده میتواند جیوه را از آب جدا کند.تستهای سم سنجی نشان داد که این پلمیر ساخته شده هیچ ضرری برای محیط زیست ندارد و میتواند در عین حال جیوه را از آب حذف کند. امیدواریم که بتوانیم ساخت این پلیمر را به مقیاس صنعتی برسانیم و در محیط زیست از آن استفاده کنیم.

فعالیتهایی همچون استخراج معادن, سوزاندن سوختهای فسیلی باعث ورود غیرمستقیم جیوه به آب میشود. میزان جیوهی ورودی به آب در عصر صنعتی دایما در حال افزایش است. حضور جیوه در آب میتواند باعث نابودی تدریجی موجودات دریایی شود. همچنین پرندگانی که از این موجودات به عنوان غذا استفاده میکنند تحت تاثیر قرار میگیرند و چرخهی آن در پایان به ضرر انسانها خواهد بود. کم شدن میزان IQ در کودکان و افزایش افسردگی از مضرات وجود جیوه در آب است. جیوه در غلظت بالا میتواند بسیار خطرناک و کشنده باشد.